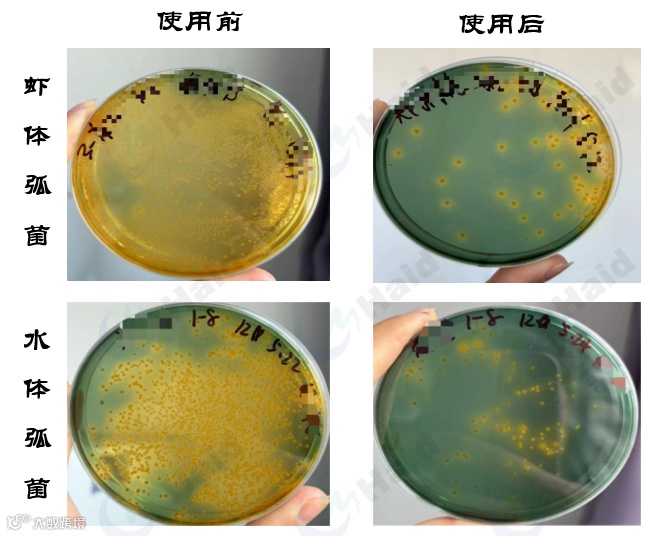

文 | 浙江海大 翟富德
受大环境影响,虾价持续走低,今年早造虾多地出现亏损情况,整体盈利率低于2成。但是,低行情下山东区域我司合作小棚园区依然强势,效益、产量双丰收!近日浙江海大东营示范园区持续出虾,胡总共计出虾64张棚,平均棚产近2000斤,单棚产值45100元!
海兴农小棚苗,5月10日出虾,规格28头,棚产2200斤,回捕率95%,价格20.5元/斤,单棚收入超4.5万元!饲料虾多康+硬壳宝,虾子体色靚、虾壳硬度高、拉虾成活率高!

综合分析我司园区去年春虾养殖情况:相较于其他苗种,海兴农苗种养殖周期缩短2天,平均棚产高134斤,平均规格大2头,平均虾价高0.3元/斤。

好的苗种是成功的开始,是成功的关键!近几年苗种问题频发,养户更倾向于大厂家苗种。通过分析我司园区投苗情况,海兴农苗种占比持续升高,2023年园区海兴农苗种占比49%,2024年园区海兴农苗种占比70%,同比上升21%。


① 微粒子工艺饲料利用率高,减少饲料溶散率及水体压力;
② 添加多种有益成分,肝脏、肠道健康度高;
③ 营养全面虾苗成活率提高6%左右。
2、中后期:虾多康+硬壳宝
虾多康:保肝、抗病、活力好。添加抗病因子及护肝因子,全面提高对虾对外界刺激的抵抗力以及肝脏的修复能力。
硬壳宝:强营养、提体色、促硬壳。营养加强长虾快,添加虾青素等多种成分提体色,搭配多种矿物质元素,提高吸收率、快速硬壳。

① 打样情况



肠道:肠道粗壮,粪便短粗,色素细胞凝集。
肝脏:研磨砖红色,白膜清晰,脂粒丰富。
离水应激实验:成活率100%,虾子活力好、体质优。
① 体色变化

投喂硬壳宝养户虾子体色明显改善:从煮虾颜色可以看出,使用硬壳宝后煮虾颜色明显加深;出虾体色对比,硬壳宝养户虾子黑红,活力好、拉虾成活率高,更受市场欢迎。
② 虾壳硬度检测
通过设备检测投喂硬壳宝前后虾子壳硬度情况,投喂之前虾壳硬度在2.2-2.3左右,投喂后虾壳硬度提升到2.9左右。

③ 卖虾价格与拉虾成活率
从卖虾数据进行分析:相对于常规料客户,硬壳宝客户虾子单斤收入高1-1.5元,单棚收入高2000-3000元,一组棚收益高8-12万元;根据拉虾水车反馈硬壳宝客户较常规料拉虾成活率高3%左右。
背景信息:东营示范园区胡总,4月21日开始投喂硬壳宝,投喂20天后效果明显!
使用效果:虾子体色黑红,虾壳硬度明显提升,肝脏、肠道健康,虾子活力好,拉虾成活率高!

浙江海大服务团队注重本土化养殖技术积累及阶段性问题防护,从试水行动、余氯处理、氮循环方案、亚盐处理方案等多方面给养户提供科学的预防、处理方案。
背景:东营示范园区刘老板,5月18号测水亚盐高,含量达到12mg/L,推荐养户使用海大亚盐防控方案,亚盐明显下降。
方案
肥水:菌藻旺2斤/棚
改底:底倍健1斤/棚
补菌:强力倍生源1包/棚、3102光合菌5斤/棚
频率:2天/次
效果:使用两次后,检测水体亚硝酸盐含量由12mg/L下降到7mg/L,虾子活力好,吃料正常。

背景:东营示范园区郑老板,5月17号检测水体、虾体弧菌超标,建议养户使用我司弧菌防控方案。
方案
虾体弧菌:清弧肽1%拌料投喂
底质管理:底倍健1斤/棚
水体弧菌:靓底1包/棚
效果:使用后虾体、水体弧菌明显减少,控制在安全值以内,虾子吃料正常、活力好!
山东小棚养殖在模式、产品、技术等各个环节都在持续优化升级。低行情下降本增效是必然,高成功率是盈利的根本。浙江海大服务团队始终坚持苗料动保协同模式推广,致力于本土化养殖技术总结,将客户利益放在首位,助力养户成功养殖。
本文系海大农牧(微信号:haid002311)原创,未经授权,一律禁止转载!文章投稿、转载授权,欢迎发邮件到:haidnm@haid.com.cn

👇 咨询产品可点击"阅读原文"留言

